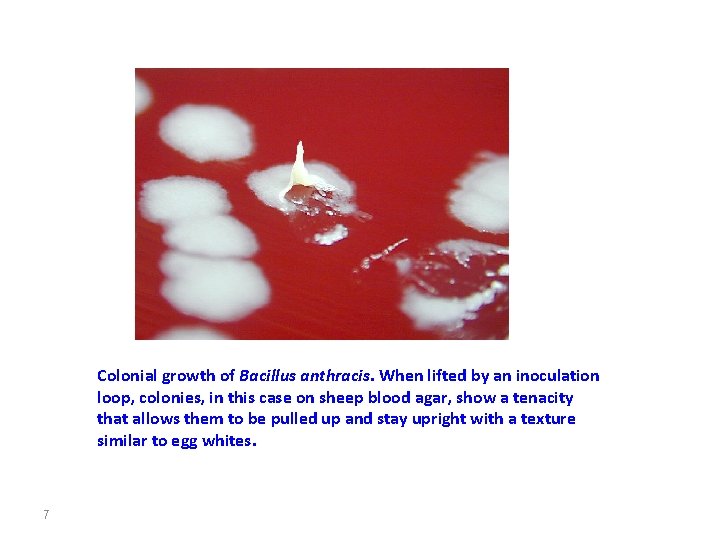
Colonial growth of Bacillus anthracis. When lifted by an inoculation loop, colonies, in this
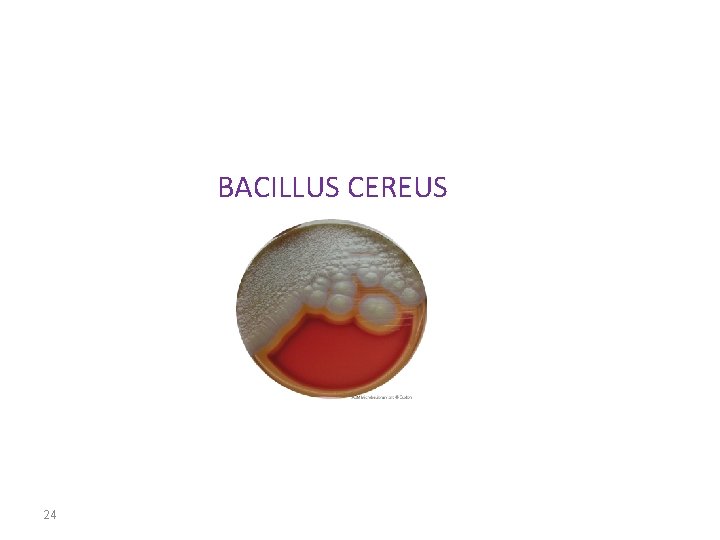
BACILLUS CEREUS 24
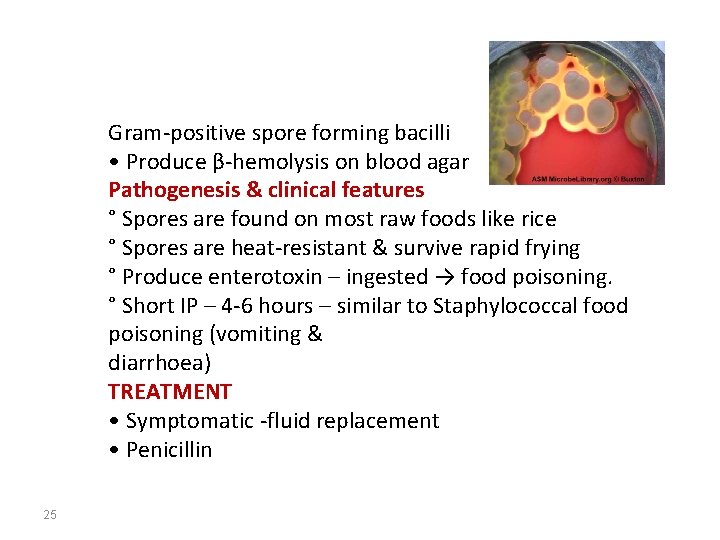
Gram-positive spore forming bacilli • Produce β-hemolysis on blood agar Pathogenesis & clinical features

Diagnostic microbiology lecture 11 Gram Positive EndosporeForming Bacilli

Diagnostic microbiology lecture: 11 Gram Positive, Endospore-Forming Bacilli THE GENUS BACILLUS Abed El. Kader Elottol MSc. Microbiology 2010 1


There are 48 species included in the genus bacillus with the following general characteristics: 1. Gram-positive bacilli 2. Spore former 3. Aerobic and facultative anaerobic THE MOST IMPORTANT PATHOGENS: 1. Bacillus anthracis 2. Bacillus cereus 3

BACILLUS ANTHRACIS 4

Morphology: 1. Large gram positive bacilli. 2. Non-motile. 3. Found singly, in pairs or in long chains. 4. Capsule could be demonstrated during growth in infected animals. 5. Spores are formed in culture, dead animal's tissue but not in the blood of infected animals. 6. Spores are oval and centrally located. Survival in Soil • Spores remain viable in soil for decades. • In World War II in Scotland spores were exploded. • Survived for >40 years and were eradicated in 1987 • Changing environmental conditions (temp. rain etc. ) help in survival and multiplication. 5

Cultural Characteristics: = Blood Agar and Nutrient Agar are commonly used to cultivate the bacilli. Plates are incubated aerobically at 37 o. C. = On blood agar plates, colonies have irregular borders and are non-hemolytic. = On nutrient agar: They are described as "Medusa head" or "Comet tail". Specimen Collection and Laboratory Diagnosis: CAUTION: Laboratory safety is very important when working with any materials suspected of containing Bacillus anthracis. 6
Colonial growth of Bacillus anthracis. When lifted by an inoculation loop, colonies, in this case on sheep blood agar, show a tenacity that allows them to be pulled up and stay upright with a texture similar to egg whites. 7

Samples are collected depending on the site affected: 1. Swab samples from cutaneous lesions and blood cultures. 2. Sputum and blood for pulmonary anthrax 3. Gastric aspirate, feces and blood for enteric anthrax. = Gram stained smears: Made from clinical samples, show large gram positive bacilli in long chains "Bamboo-like appearance". = Giemsa stained smears: Purple bacilli with red capsule. = Culture. =Animal inoculation test: Experimental animals are injected intraperitoneally by a suspension of the test organism "Suspected B. anthracis culture". The animal dies in 48 -96 hours due to respiratory failure. Large number of typical bacilli can be found in the blood and tissue of spleen of the infected animal. 8

Gram stain of Bacillus anthracis showing Gram-positive rods forming long filaments. “Bamboo –like appearance” 9

showing endospores as green and the vegetative cell as red 10

= Biochemical Identification: 1. Carbohydrate fermentation test: 2. Gelatine liqefaction test: Negative after 7 days. Growth has a characteristic appearance of an inverted pine tree. 3. Nitrate reduction test: Positive 4. Starch hydrolysis test: Positive 5. Voges-Proskauer test: Positive 6. Sensitivity to penicillin. Sensitive 7. Lysis by gamma phages: Positive. This test accurately differentiate B. anthracis from other bacilllus species. 11


Lysis of Bacillus anthracis by the lytic phage gamma. The plaque (clear area) in the region of confluent growth is where the gamma phage was applied. The plaque results from the phage's. 13

14

PATHOLOGY; There are different clinical forms of anthrax: 1. CUTANEOUS ANTHRAX: 95 -98% of anthrax cases are of this type. Infection occur through wounds, burns, which may progress to toxaemia and septicemia. The site of entry often produces a painless blister referred to as Malignant pustule. 2. ENTERIC "INTESTINAL" ANTHRAX: Caused by the ingestion of infected meat. This form of the disease is severe and fatal. 3. PULMONARY ANTHRAX: Caused by the inhalation of large number of B. anthracis spores. It is usually fetal. This clinical form is commonly known as "wool sorter disease". 15

16

Rod of B anthrax in lung Tissue 17

18

19

ANTIGENIC STRUCTURE AND PATHOGENIC DETERMINANTS: 1. The Capsular Polypeptide: Composed of poly peptide of a high molecular weight consisting of D-glutamic acid. 2. Polysaccharide Somatic Antigen: Composed of N acetulglucoseamine and Dgalactose. 3. Complex Protein Toxin: This toxin appear to be responsible for signs and symptoms characteristic of anthrax. Accumulation of the toxin in tissue and its effect on the central nervous system results in death by respiratory failure and anoxia. TREATMENT: Penicillin is the drug of choice. For penicillin-sensitive patients, tetracycline, erythromycin, chloramphenicol and streptomycin may be given as alternative drugs. 20

21

22

Bacillus anthracis has long been considered a potential biological warfare agent and the events following September 11 give cause for concern to the West. 23
BACILLUS CEREUS 24
Gram-positive spore forming bacilli • Produce β-hemolysis on blood agar Pathogenesis & clinical features ° Spores are found on most raw foods like rice ° Spores are heat-resistant & survive rapid frying ° Produce enterotoxin – ingested → food poisoning. ° Short IP – 4 -6 hours – similar to Staphylococcal food poisoning (vomiting & diarrhoea) TREATMENT • Symptomatic -fluid replacement • Penicillin 25

Characteristic 26 B. anthracis B. cereus growth requirement for thiamin + - hemolysis on sheep blood agar - + glutamyl-polypeptide capsule + - lysis by gamma phage + - motility - + growth on chloralhydrate agar - + string-of-pearls test + -

END of LECTURE 27
- Slides: 27